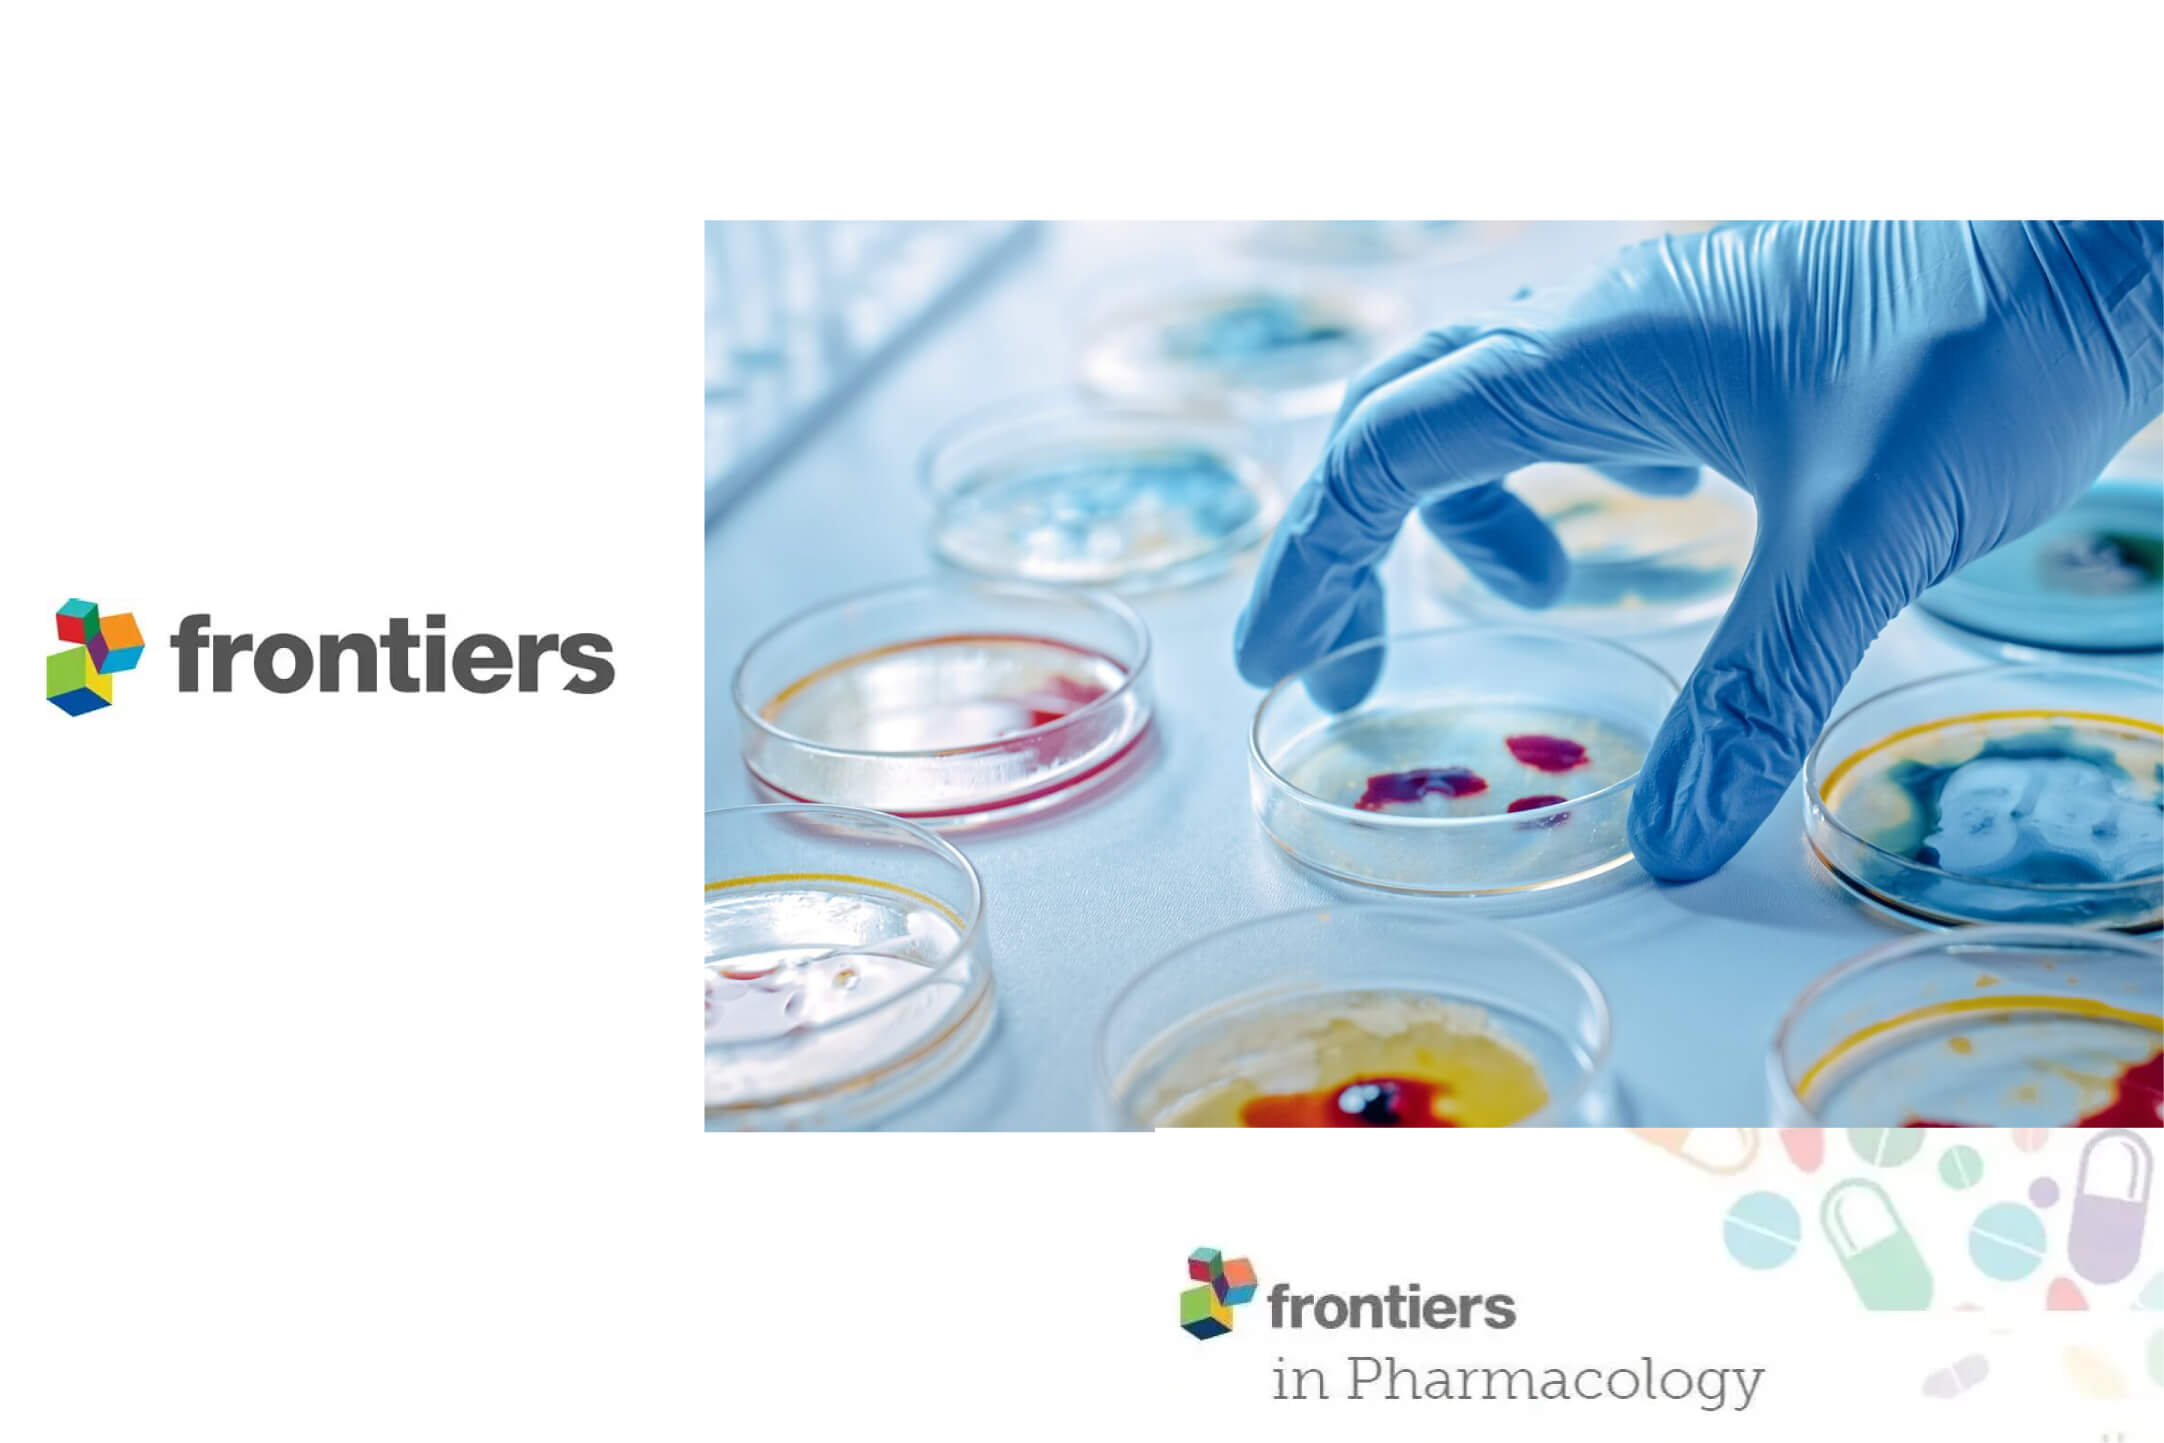

IF:8.3
GDNF signaling modulation by Akkermansia muciniphila ameliorates constipation–depression comorbidity in Parkinson’s disease
Chunyan Mu, Zairen Zhou, Jingyu Li, Mingyu Su, Ke Xue, Jingyuan Zhang, Shijie Shi, Ye Li, Xiaoyu Yao, Mengxue Wang, Wanxiang Zhang, Zhe Wang, Jianguo Zhu, Shuguang Fang
npj Parkinson's Diease丨丨引用竞技宝电竞产品:H804008 细胞培养瓶 H803000 6孔细胞培养板
2025-11-28